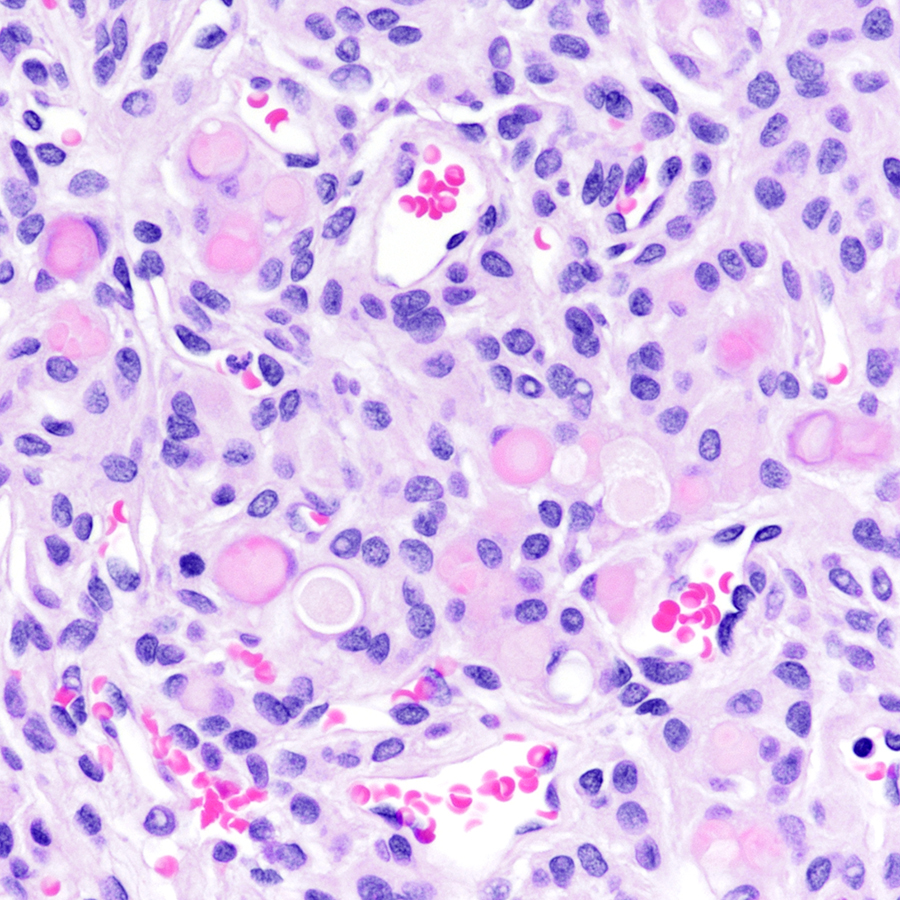
CraigHorbinski's tweet image. Dura-based tumor in an adult. Diagnosis? What mutation might this tumor contain? (It's not a SECRET.) #pathology #neuropath #PathTwitter
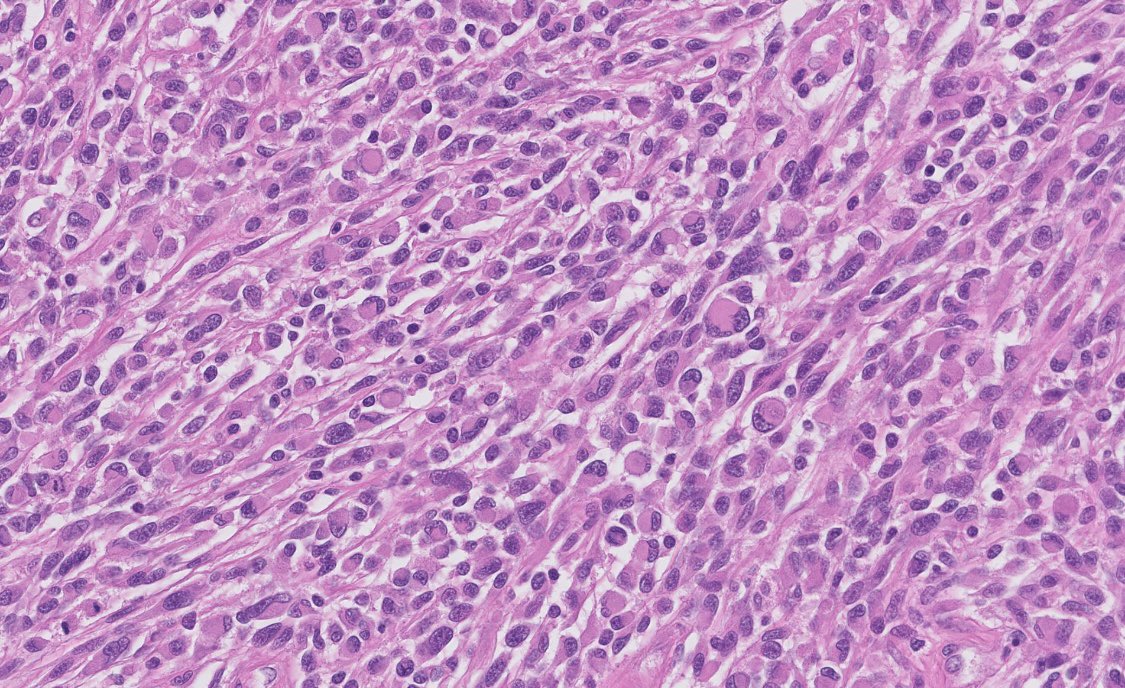
PeterKobalka's tweet image. Yes, this is met epithelioid GBM!  Below, original resection, GFAP, olig-2, then one of the LN Mets #neuropathology #cnspath #neuropath
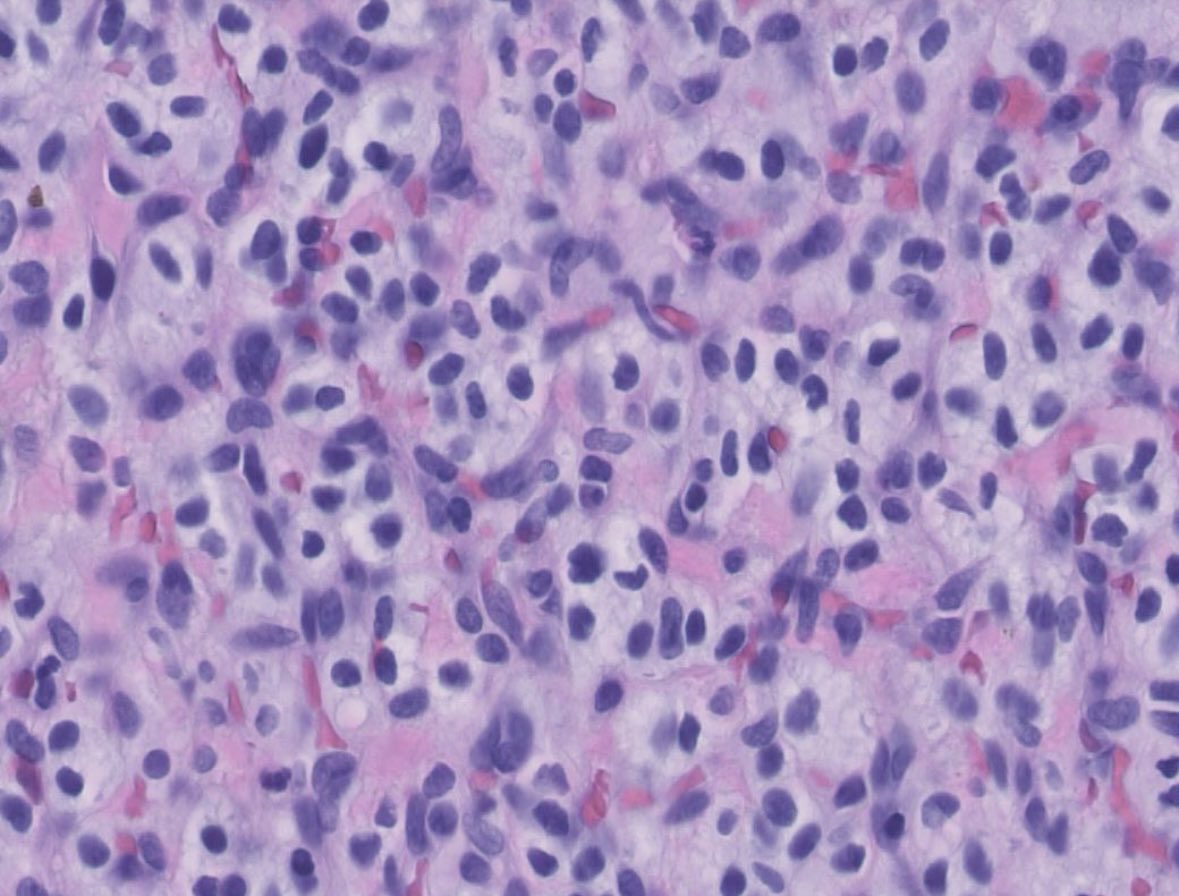
PeterKobalka's tweet image. Hemangioblastoma, Inhibin+. Young pt, must work up for VHL! (Trainees; this is the MOST POPULAR tumor syndrome for testing) #cnspath #neuropath #neuropathology #pathx #pathtwitter
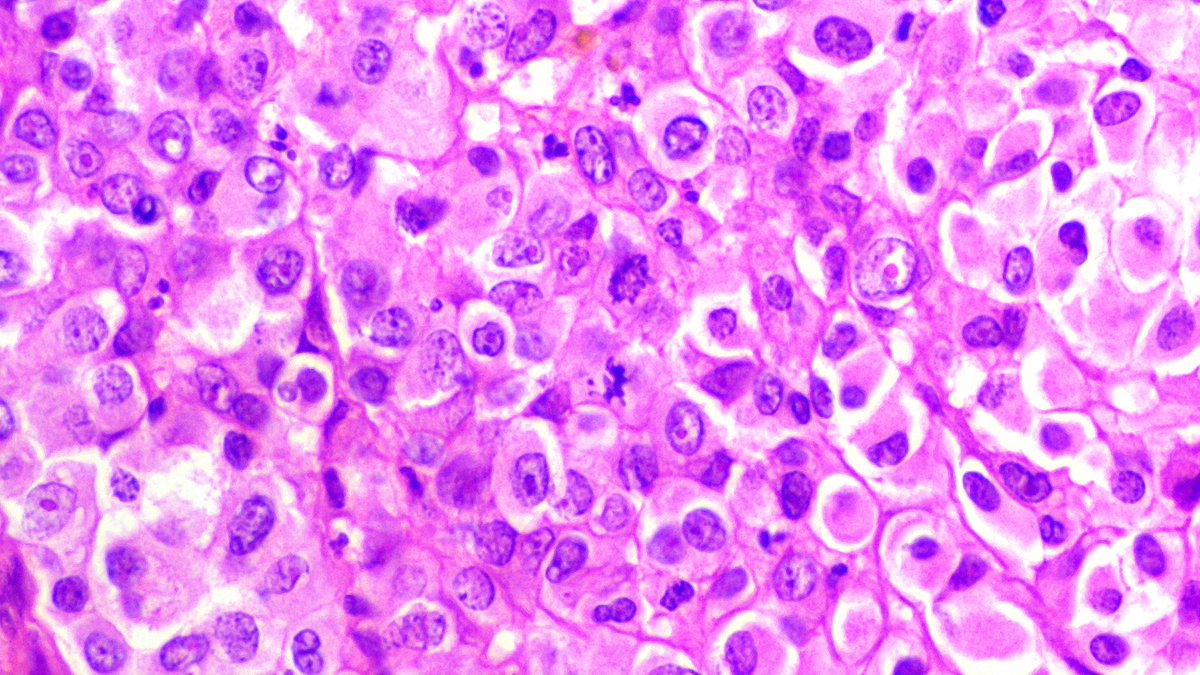
_Wondweson64's tweet image. ᴀ 16 ʏʀ 👩 | ᴍɪᴅᴅʟᴇ ᴄʀᴀɴɪᴀʟ ғᴏssᴀ ᴇxᴛʀᴀ-ᴀxɪᴀʟ ᴍᴀss🧠.
🌒 Rʜᴀʙᴅᴏɪᴅ ᴍᴇɴɪɴɢɪᴏᴍᴀ
#pathx #pathology #CNSpath #pathresidents #pathoutpic

#cnspath 検索結果
Meningioma displaying necrosis with pseudo pallisading. Not just a feature seen in some high-grade gliomas! #cnspath #neuropath #neuropathology #pathtwitter #pathx


Glioblastoma with serpiginous pseuopalisading necrosis, a very interesting pattern indeed! #neuropath #cnspath #neuropathology #pathtwitter #pathx



Yes, this is met epithelioid GBM! Below, original resection, GFAP, olig-2, then one of the LN Mets #neuropathology #cnspath #neuropath




This spine mass was submitted as “rule out ependymoma.” Thoughts? Stains? Dx? #cnspath #neuropath #neuropathology #pathx #pathtwitter




Pituitary, contents of Rathke’s Cleft Cyst. The colloid-like material really looks like colloid, esp on the Diff-quik! (And maybe some cracking too) #neuropathology #neuropath #cnspath #pathx #pathtwitter #cytology #cytopath #cytopathology




Brain mets generally don’t infiltrate. However, small cell carcinoma and melanoma sometimes do, probably a result of shared embryologic origin (I.e. neuroectoderm) #pathx #pathtwitter #cnspath #neuropath #neuropathology

61F never smoker, large axillary mass with widespread Mets including multiple brain Mets. CD10 strongly positive (shown). Mutations in p53, RB1, and TERT. DDx? Stain suggestions? #pathx #pathtwitter #cnspath #neuropath #neuropathology




Embolization material in a meningioma; not just black or white in color, apparently! What is the purpose of embolizing vessels in meningiomas (and other highly vascularized neoplasms)? #pathx #pathtwitter #cnspath #neuropath #neuropathology



Hemangioblastoma, Inhibin+. Young pt, must work up for VHL! (Trainees; this is the MOST POPULAR tumor syndrome for testing) #cnspath #neuropath #neuropathology #pathx #pathtwitter




Dedifferentiated chordoma, metastatic to the lung. Without clinical hx, these can be very difficult to recognize, as Brachyury often negative (as it is here). #pathtwitter #pathx #cnspath #neuropath #neuropathology




What do you call this? Non-enhancing 16mm lesion cerebellum, middle aged female. More pictures and poll below. #pathx #pathtwitter #cnspath #neuropath #neuropathology




Large choroidal melanoma with perineural invasion and >5mm extraocular extension. This alone gets it to pT4e. Unsurprisingly, a liver mass soon developed #pathx #pathtwitter #cnspath #neuropath #neuropathology



65/f, proptosis,conjunctival chemosis, orbital mass, MRI- well demarcated,intraconal mass,post.inf.lateral aspect,adherent to optic nerve sheath complex,3.5x2.2x3.1cm.#cnspath,#eyeyepath,#neuropath,@eyepathlondon @CraigHorbinski @NeuroEyepath @aanchalkakkar




Also a great stain for gonadotroph-type PitNET! #cnspath #neuropath #neuropathology
1/2 2YOM with recurring seizures. Imaging shows large brain parenchymal mass-The surgeons say it appears "extra axial"...attached to the falx but not infiltrating the brain. This looks like embryonal tumour with abundant neuropil and rosettes (now ETMR) to me #CNSPath #Neuropath




Probably the ugliest met prostate adenocarcinoma to brain I’ve seen. Fun fact: prostate strongly prefers the meninges and only very rarely gets in the brain. #neuropath #cnspath #neuropathology #pathtwitter #pathx




2/Fch Posterior fossa SOL @Gowri_passionP @ashokparameswar @atman_ci @TristanRutland7 #CNSpath More pictures in the thread




61F never smoker, large axillary mass with widespread Mets including multiple brain Mets. CD10 strongly positive (shown). Mutations in p53, RB1, and TERT. DDx? Stain suggestions? #pathx #pathtwitter #cnspath #neuropath #neuropathology




Hemangioblastoma, Inhibin+. Young pt, must work up for VHL! (Trainees; this is the MOST POPULAR tumor syndrome for testing) #cnspath #neuropath #neuropathology #pathx #pathtwitter




Embolization material in a meningioma; not just black or white in color, apparently! What is the purpose of embolizing vessels in meningiomas (and other highly vascularized neoplasms)? #pathx #pathtwitter #cnspath #neuropath #neuropathology



2/Fch Posterior fossa SOL @Gowri_passionP @ashokparameswar @atman_ci @TristanRutland7 #CNSpath More pictures in the thread




Dedifferentiated chordoma, metastatic to the lung. Without clinical hx, these can be very difficult to recognize, as Brachyury often negative (as it is here). #pathtwitter #pathx #cnspath #neuropath #neuropathology




What do you call this? Non-enhancing 16mm lesion cerebellum, middle aged female. More pictures and poll below. #pathx #pathtwitter #cnspath #neuropath #neuropathology




Glioblastoma with serpiginous pseuopalisading necrosis, a very interesting pattern indeed! #neuropath #cnspath #neuropathology #pathtwitter #pathx



Meningioma displaying necrosis with pseudo pallisading. Not just a feature seen in some high-grade gliomas! #cnspath #neuropath #neuropathology #pathtwitter #pathx


This spine mass was submitted as “rule out ependymoma.” Thoughts? Stains? Dx? #cnspath #neuropath #neuropathology #pathx #pathtwitter




Pituitary, contents of Rathke’s Cleft Cyst. The colloid-like material really looks like colloid, esp on the Diff-quik! (And maybe some cracking too) #neuropathology #neuropath #cnspath #pathx #pathtwitter #cytology #cytopath #cytopathology




Large choroidal melanoma with perineural invasion and >5mm extraocular extension. This alone gets it to pT4e. Unsurprisingly, a liver mass soon developed #pathx #pathtwitter #cnspath #neuropath #neuropathology



#Cnspath Secretory meningioma @CraigHorbinski
Dura-based tumor in an adult. Diagnosis? What mutation might this tumor contain? (It's not a SECRET.) #pathology #neuropath #PathTwitter
Probably the ugliest met prostate adenocarcinoma to brain I’ve seen. Fun fact: prostate strongly prefers the meninges and only very rarely gets in the brain. #neuropath #cnspath #neuropathology #pathtwitter #pathx




2/2 @CraigHorbinski @neuropathmk @bitar_mireille @mlage @FRodriguezNP #CNSPath #NeuroPath #PathTwitter #PathX



1/2 2YOM with recurring seizures. Imaging shows large brain parenchymal mass-The surgeons say it appears "extra axial"...attached to the falx but not infiltrating the brain. This looks like embryonal tumour with abundant neuropil and rosettes (now ETMR) to me #CNSPath #Neuropath




Thank you! I will be sharing another for the #CNSPath team later in the day.🙏🏽
Kindly share your thoughts on this case: Intraventricular mass in a 38 year old Male. 1/2 @CraigHorbinski @neuropathmk @bitar_mireille @mlage @FRodriguezNP #CNSPath #NeuroPath #PathTwitter #PathX




#Cnspath metastatic carcinoma
Brain lesion in a woman with an abdominal mass. Based on the morphology, what kind of metastatic cancer do you think this might be? #pathology #neuropath #PathTwitter


Meningioma displaying necrosis with pseudo pallisading. Not just a feature seen in some high-grade gliomas! #cnspath #neuropath #neuropathology #pathtwitter #pathx


Yes, this is met epithelioid GBM! Below, original resection, GFAP, olig-2, then one of the LN Mets #neuropathology #cnspath #neuropath

Glioblastoma with serpiginous pseuopalisading necrosis, a very interesting pattern indeed! #neuropath #cnspath #neuropathology #pathtwitter #pathx



Embolization material in a meningioma; not just black or white in color, apparently! What is the purpose of embolizing vessels in meningiomas (and other highly vascularized neoplasms)? #pathx #pathtwitter #cnspath #neuropath #neuropathology



61F never smoker, large axillary mass with widespread Mets including multiple brain Mets. CD10 strongly positive (shown). Mutations in p53, RB1, and TERT. DDx? Stain suggestions? #pathx #pathtwitter #cnspath #neuropath #neuropathology




This spine mass was submitted as “rule out ependymoma.” Thoughts? Stains? Dx? #cnspath #neuropath #neuropathology #pathx #pathtwitter




What do you call this? Non-enhancing 16mm lesion cerebellum, middle aged female. More pictures and poll below. #pathx #pathtwitter #cnspath #neuropath #neuropathology




Hemangioblastoma, Inhibin+. Young pt, must work up for VHL! (Trainees; this is the MOST POPULAR tumor syndrome for testing) #cnspath #neuropath #neuropathology #pathx #pathtwitter

Pituitary, contents of Rathke’s Cleft Cyst. The colloid-like material really looks like colloid, esp on the Diff-quik! (And maybe some cracking too) #neuropathology #neuropath #cnspath #pathx #pathtwitter #cytology #cytopath #cytopathology




65/f, proptosis,conjunctival chemosis, orbital mass, MRI- well demarcated,intraconal mass,post.inf.lateral aspect,adherent to optic nerve sheath complex,3.5x2.2x3.1cm.#cnspath,#eyeyepath,#neuropath,@eyepathlondon @CraigHorbinski @NeuroEyepath @aanchalkakkar




Dedifferentiated chordoma, metastatic to the lung. Without clinical hx, these can be very difficult to recognize, as Brachyury often negative (as it is here). #pathtwitter #pathx #cnspath #neuropath #neuropathology




Brain mets generally don’t infiltrate. However, small cell carcinoma and melanoma sometimes do, probably a result of shared embryologic origin (I.e. neuroectoderm) #pathx #pathtwitter #cnspath #neuropath #neuropathology

Large choroidal melanoma with perineural invasion and >5mm extraocular extension. This alone gets it to pT4e. Unsurprisingly, a liver mass soon developed #pathx #pathtwitter #cnspath #neuropath #neuropathology



Probably the ugliest met prostate adenocarcinoma to brain I’ve seen. Fun fact: prostate strongly prefers the meninges and only very rarely gets in the brain. #neuropath #cnspath #neuropathology #pathtwitter #pathx




2/Fch Posterior fossa SOL @Gowri_passionP @ashokparameswar @atman_ci @TristanRutland7 #CNSpath More pictures in the thread




ᴀ 16 ʏʀ 👩 | ᴍɪᴅᴅʟᴇ ᴄʀᴀɴɪᴀʟ ғᴏssᴀ ᴇxᴛʀᴀ-ᴀxɪᴀʟ ᴍᴀss🧠. 🌒 Rʜᴀʙᴅᴏɪᴅ ᴍᴇɴɪɴɢɪᴏᴍᴀ #pathx #pathology #CNSpath #pathresidents #pathoutpic

1/2 I need your thoughts on this; 10-year old with a sudden onset of left hemiparesis and recurrent seizures. CT-right parietal lesion with associated haematoma MRI shows a well-circumscribed lesion with a "popcorn" appearance. Working diagnosis: Cavernous malformation #CNSPath




Kindly share your thoughts on this case: Intraventricular mass in a 38 year old Male. 1/2 @CraigHorbinski @neuropathmk @bitar_mireille @mlage @FRodriguezNP #CNSPath #NeuroPath #PathTwitter #PathX




Something went wrong.
Something went wrong.
United States Trends
- 1. #Survivor50 N/A
- 2. #AEWDynamite N/A
- 3. Cade and Paolo N/A
- 4. Matt Olson N/A
- 5. #LetEmKnow N/A
- 6. Jim Crow N/A
- 7. Sydney Taylor N/A
- 8. Cirie N/A
- 9. David Peterson N/A
- 10. Kevin Knight N/A
- 11. Letang N/A
- 12. Supreme Court N/A
- 13. Kenley Jansen N/A
- 14. #Cavs N/A
- 15. Scottie Barnes N/A
- 16. Matty O N/A
- 17. Mr. Beast N/A
- 18. Devens N/A
- 19. #ChicagoFire N/A
- 20. Divine Dominion N/A
















